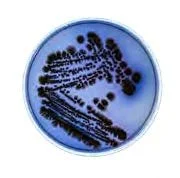

ONTOLOGY OF SCENT
Designing with volatile atmospheres
Photography by Julia Brière unless otherwise stated
2021 | Academic | Team Project
COLLABORATORS Laboratory | Hana Cvelbar, Julia Brière Fabrication | Penn Ryan, Julia Brière, Hana Cvelbar Computation | Satyam Gyanchandan
This project treats scent as a spatial medium. The work investigates how atmospheric materials can support human well-being by providing sensory grounding. The living membrane emits a natural scent linked to calming parasympathetic responses, reducing stress and redirecting attention. Rather than using screens or visual cues, the system alters the atmosphere itself. It creates environments that are sensed and felt, offering gentle behavioral guidance and reframing scent as an architectural medium. A hydrogel-bacteria composite releases scent in response to humidity and airflow, creating an active material that shifts over time.
ROLE Concept Development and Design, Hydrogel Development, Weaving Logic, Material-to-Architecture Translation, Fabrication,
Its behavior is shaped by environmental conditions, not by static form. Computational analysis of air movement and microclimates informed the system’s geometry, determining how airborne compounds concentrate, disperse, and travel across space. The woven membrane is positioned where scent needs to intensify, slow, or diffuse, resulting in an atmosphere defined by material behavior rather than visual expression.
01 LABORATORY
Bacterial cultivation
The project begins with Streptomyces coelicolor, a soil bacterium that produces geosmin, the molecule responsible for the smell of rain. The scent is not synthetic or applied; it arises from metabolic processes within the material itself. Growth experiments established the conditions that intensify scent production. Cultures grown in darker, humid environments with specific nutrient media produced stronger and more complex volatile profiles. Its output shifts with temperature, moisture, and colony maturity. These parameters later informed how the living material is embedded in the spatial system.
Hydrogel embedded in 3D printed structure
02 LABORATORY
Hydrogel development
To host the bacteria, a hydrogel matrix combining sodium alginate and k-carrageenan was developed. The ratio was tuned for two requirements: structural integrity for robotic extrusion, and porosity that sustains bacterial life. Calcium chloride cross-linking allows the gel to solidify on contact, enabling controlled deposition and layering.
Results
Electronics served as a feedback layer connecting biological performance to spatial design
Confirmed correlation between bacterial growth stage and VOC increase
Control tests at varying temperature and humidity confirmed that PPM increases were driven by bacterial VOCs
Data used to locate active material zones and inform architecture
R2A Big Petri Dish Week-5 culture
03 LABORATORY
Setup Arduino UNO with MQ-2 and DHT11 sensor, and bacterial sample
VOC sensing to measure bacterial smell
To confirm that Streptomyces coelicolor produces detectable volatile compounds, a VOC sensing setup was built using an MQ-2 gas sensor. Cultures grown on various media and at different growth stages were tested over time, demonstrating variation in VOC output across samples. The data shown here is from one representative sample (week-5 culture on R2A), and validates that scent production can be quantified, compared, and used to bridge biological behavior, data, and design decisions.
VOC Measurements Week 5 VOC Increase
04 FABRICATION
Hydrogel exstrusion
The goal of this phase was to produce hydrogel fibers suitable for weaving, focusing on flexibility, strength, and responsiveness. Multiple fiber diameters and geometries were tested to understand how extrusion parameters affected performance. Early trials were done by hand to tune viscosity and flow; later stages used robotic extrusion for precision and repeatability.
Fiber strands: 97 cm to 0.3 cm
Green woven fibers on loom | CH-Na Alginate 4:7 0.2% acetic acid
Manually extruded mesh
Jute fibers embedded in hydrogel | CH-Na Alginate 3:4 0.5% acetic acid
Woven fibers on loom | CH-Na Alginate 3:4 0.5% acetic acid
Hydrogel embedded in woven jute | CH-Na Alginate 3:4 0.5% acetic acid
Triangle extrusion without loom
Nonplanar extrusions onto fabric support
150 x 200 mm
100 x 100mm
3D printed structure as extrusion support
05 FABRICATION
Robotic weaving
The hydrogel’s tensile properties allow it to be woven rather than cast. Robotic toolpaths extrude interlocking strands to build a mesh that holds tension and bonds to itself. Paths were generated parametrically, controlling layer height, strand spacing, and weave density. The WASP delta printer handled planar looms, while the Kuka KR6 printed on curved surfaces with the nozzle kept perpendicular.
A serpentine path links each layer's endpoint to the next layer's start, enabling continuous stacking. Bacteria mixed into the gel remain active, with pigmentation spreading through the woven membrane over time. The result is a living textile that can be fabricated at architectural scale and placed where atmospheric modulation is needed.
100mm diameter
06 FABRICATION
Manual weaving
To scale up, the final form was manually woven. This sample demonstrated better moisture retention compared to individual hydrogel fibers. However, manual extrusion resulted in irregular and non-homogeneous fibers.
Hydrogel fibers woven into 3D structure, week 4 of bacterial growth | Photo: Hana Cvelbar
S. coelicolor integrated into hydrogels | Photo: Hana Cvelbar
07 COMPUTATION
Environmental analysis
Computational simulations informed where and how the scent membrane should behave. Fluid dynamics models mapped sun exposure, wind velocity, and airflow turbulence across the site, translating these conditions into spatial constraints. Areas with sufficient warmth and shade identified zones that support bacterial activity. Wind patterns defined how scent would accumulate or disperse. The final geometry emerged from aligning these environmental gradients with the membrane's metabolic needs.
VOC simulation with multiple emitters dispersing through the interior of a vector field geometry
08 COMPUTATION
Atmospheric geometry
Wind velocity fields generated in Houdini were converted into volume trails mapping how air moves across the site. These trails were then meshed to produce surfaces that guide, slow, or redirect airflow. Additional simulations tested how scent would behave within these geometries, identifying areas where it would collect, disperse, or fade.
VOC simulation on vector geometry
The final structure is layered: primary scaffolds set circulation and enclosure. Secondary surfaces, informed by vapor simulations, carry the living membrane and shape its exposure. Boolean operations open or close passages where scent intensifies or transitions. The architecture does not contain scent but shapes the conditions that produce it.
09 3D MODELS
Translating material research into user-centered spatial models
The project uses 3D modeling to connect material research with lived experience, envisioning how people would inhabit and sense spaces shaped by the responsive membrane.